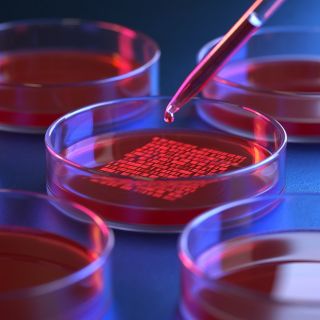
Genome Editing

‘Embodiment of U CAN @ UC’: Thousands of UC students graduate, celebrate personal triumphs and look to the future
Nearly 3,000 graduates have joined the University of Canberra’s growing alumni ranks, as nationally renowned guest speakers shared words of wisdom.
Read more about slide
Exceptional UC staff recognised at 2025 Staff Awards
Nineteen winners have been announced over a variety of categories at the 2025 UC Staff Awards.
Read more about slide
Five UC alumni inducted to the Sport Walk of Fame
Five University of Canberra alumni have been recognised for their contributions to their respective sport and sport-related disciplines and inducted to the University’s Sport Walk of Fame.
Read more about slideNews
Latest News
-

UC shows commitment to early learning, joins Thrive by Five campaign
More on UC shows commitment to early learning, joins Thrive by Five campaignThe University of Canberra supports calls for reform of the early education system, partnering with the Minderoo Foundation’s Thrive by Five campaign.
-
UC collaboration brings citizens’ jury to Canberra
More on UC collaboration brings citizens’ jury to CanberraThe University of Canberra and the University of Tasmania will bring 24 ordinary citizens together in Canberra, to debate the social, ethical and legal arguments of genome editing.
-

UC’s future campus vision unveiled
More on UC’s future campus vision unveiledThe University of Canberra has unveiled its plans for the future of its Bruce campus, with a new 20-year Campus Master Plan released today.
-

UC’s gender equality support goes global
More on UC’s gender equality support goes globalThe University of Canberra will host an official event for the United Nation’s Commission on the Status of Women streamed across the UN’s international platforms.
-

UC researcher calling on teenagers to have their say in schoolyard designs
More on UC researcher calling on teenagers to have their say in schoolyard designsA University of Canberra researcher is running a competition for adolescents to have their say in what they want, and need, in public outdoor spaces.
Contact us
Can’t find what you need?
Contact the
Media and Communications Team
0408 826 362
UCMedia@canberra.edu.au
Suggest a story
Do you have some great news to share? Email us at UCMedia@canberra.edu.au
UnCover magazine